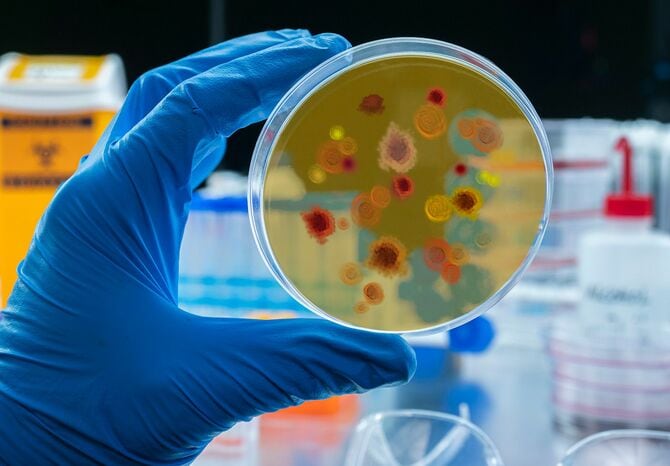
シャーレのマラリアウイルス

命を奪う感染症の発症率が低い血液型は何か。大阪大学名誉教授の深瀬浩一さんは「分子生物学の分析によると、最初に存在した血液型はA型だとわかっている。しかし人間の血液型がA型だけだった場合、A型にとってリスクの高い感染症が流行すれば、人類は滅亡に至るため、命を奪う感染症に罹りにくい血液型が生まれた」という――。
※本稿は、深瀬浩一『血液型でわかる 病気とケガのリスク』(宝島社)の一部を再編集したものです。
もっとも多くの命を奪い続ける病気
新型コロナウイルス感染症だけでなく、O型のリスクが低い感染症はほかにもあります。その代表格が「マラリア」です。
マラリアは、感染症のなかでも、世界でもっとも多くの命を奪い続けている病気の1つです。熱帯から亜熱帯の地域で多く見られることから、日本では非常に稀な感染症ですが、世界では今も年間3~5億人が感染し、約100万人が命を落としています。
過去数千年にわたって人類の歴史に大きな影響を与えてきたことから、結核やHIV(ヒト免疫不全ウイルス)とともに「世界3大感染症」に数えられています。
マラリアは、「マラリア原虫(プラスモディウム)」という寄生虫によって引き起こされる病気です。ただ、直接的にマラリア原虫がヒトに感染するのではなく、「ハマダラカ」という蚊を介して感染が広がります。
マラリアに感染している人の血を吸った蚊が自らの体内に原虫を取り込み、次に別の人を刺すときに、唾液とともにその原虫を注入して新たな感染が成立するのです。
マラリア原虫は、まず肝臓の細胞に入り込んで増殖し、赤血球に移動して再び増殖します。その後、赤血球を破裂させて外に出てきた原虫たちが、別の赤血球へと感染する――このサイクルがくり返されることで、体内で赤血球が次々と破壊されていきます。